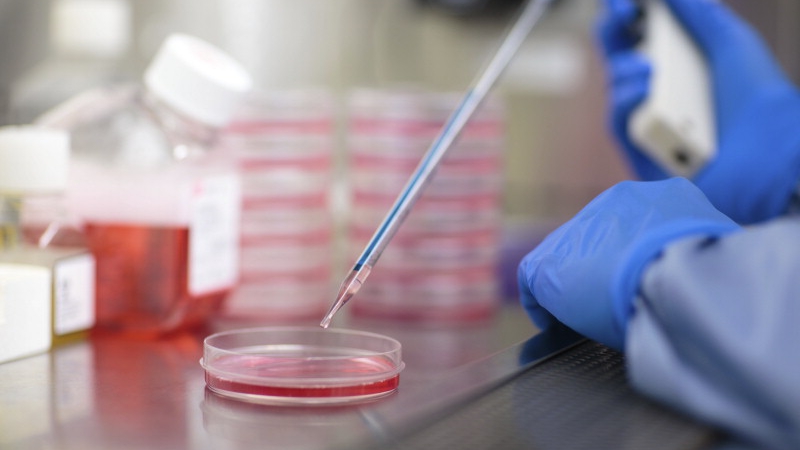

Científicos han diseñado biomateriales que podrían regenerar tejido capaz de restaurar huesos y nervios lesionados.
Los investigadores de Mayo Clinic están estudiando formas para diseñar tejido similar al humano con el fin de reforzar la capacidad que tiene el cuerpo para cicatrizar. Los científicos del Regenerative Medicine Biomaterials and Biomolecules Lab (Laboratorio de Biomateriales y Biomoléculas para Medicina Regenerativa) han diseñado biomateriales que podrían regenerar tejido capaz de restaurar huesos y nervios lesionados.
Descubrieron que los biomateriales son derivados de polímeros y son biodegradables. Cuando se utilizan junto con factores de crecimiento para formar andamios, estos materiales son capaces de reclutar células que crecen en sustitutos óseos y nerviosos. Los andamios son dispositivos que contribuyen a la generación de tejido. A medida que el tejido nuevo se va desarrollando, los materiales sintéticos se descomponen gradualmente y no dejan huella de su existencia en el cuerpo.
“La hipótesis de este trabajo es que estos biomateriales podrán funcionar como material de andamiaje al cuál las células se unirán una vez presentes en el cuerpo humano y, así, podrán asistir a la regeneración del tejido. Simultáneamente, se degradarán de manera controlada y desaparecerán al final del proceso y darán lugar a un tejido vivo completamente natural”, afirma la Dra. Lichun Lu, profesora de Ortopédica e Ingeniería Biomédica en el Laboratorio de Biomateriales y Biomoléculas.
Con el apoyo del Centro para la Medicina Regenerativa, la Dra. Lu lidera un equipo de investigadores que están desarrollando biomateriales compatibles con el cuerpo humano. Según los investigadores, dichos materiales pueden manipularse para desempeñar diversas funciones. Entre los ejemplos se encuentra un andamio sintético para nervios con la capacidad de llevar señales eléctricas desde el cerebro y un andamio óseo artificial lo suficientemente poroso como para integrar vasos sanguíneos nuevos.
“Hemos estado desarrollando biomateriales más sofisticados y multifuncionales que pueden interactuar con las células para la generación de tejido. Estos materiales ofrecen numerosas funciones semejantes al entorno natural del cuerpo. Refuerzan la adhesión celular, la proliferación y el crecimiento de tejido”, dice Lu.
Otro objetivo de esta investigación es mejorar el suministro de medicamentos en el organismo; papel fundamental que el tejido desempeña para la buena salud.
Regeneración de nervios
Millones de personas padecen de daño en los nervios periféricos, trastorno que obstaculiza actividades cotidianas como caminar, hablar y agarrar objetos. El equipo de la Dra. Lu ha desarrollado biomateriales para que funcionen como un andamio tubular que se adhiera a los nervios dañados activando, así, la regeneración del tejido.
El equipo espera que esta estrategia de regeneración del tejido pueda, algún día, utilizarse también para restaurar señales eléctricas entre el cerebro y el resto del cuerpo en personas con lesiones en la médula espinal.
“Hemos desarrollado conductos multicanales que pueden colocarse en la parte lesionada de la columna para restaurar la señal eléctrica y recrear las funciones pedidas de los pacientes”, afirma la Dra. Lu.
Actualmente, los andamios tubulares en nervios periféricos se están probando en estudios de seguridad para seres humanos.
Regeneración ósea
Algunas enfermedades o traumas pueden provocar un daño demasiado extenso como para que el cuerpo humano pueda sanarlo por sí mismo. El equipo de la Dra. Lu está investigando maneras de diseñar andamios que desencadenen la capacidad del cuerpo para recrear tejido para sustituir las células óseas faltantes, enfermas o muertas. La solución del equipo: andamios biodegradables que pudieran brindar una alternativa a los dispositivos artificiales que suelen ser ineficaces o generan infecciones.
“Esperamos desarrollar un andamio óseo que sea antiinflamatorio y resistente a las bacterias”, indica el Dr. Xifeng Liu, investigador dentro del Laboratorio de Biomateriales y Biomoléculas. “Asimismo, podemos diseñar andamios que recluten células germinales adyacentes para generar tejido y acelerar el proceso de regeneración ósea”.
El equipo se encuentra estudiando si este tipo de regeneración ósea podría ser una alternativa para las jaulas de polímero no degradable que se emplean en las cirugías de fusión vertebral. No obstante, esa solución podría llevar muchos más años de investigación. En la actualidad, el equipo está probando los andamios en grades estudios con animales y espera que la investigación avance hacia estudios de seguridad en seres humanos en un plazo de cinco a 10 años.
- Día Internacional del Yoga: cómo la alimentación puede influir en la energía, la concentración y la recuperación - 21 junio, 2026
- Estrés financiero en hombres y padres proveedores: cómo prevenir impacto en la salud - 21 junio, 2026
- CEO Club - 20 junio, 2026

